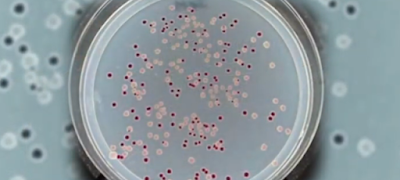

68,000 bacterial generations prove: EVOLUTION IS NOT HAPPENING
Richard Lenski began his long-term bacterial experiment on February 24, 1988, to prove that evolution is taking place. Today, after more than 68,000 generations of bacteria, we can scientifically (based on observations) find that no evolution has occurred in bacteria. This is also confirmed by research:
https://www.ncbi.nlm.nih.gov/pubmed/26833416
" We conclude that the rarity of the LTEE mutant was an artifact of the experimental conditions and not a unique evolutionary event. No new genetic information (novel gene function) evolved."
No new genetic information (new gene function) evolved. Instead, two out of 12 strains have already died out due to genetic degradation. This can be well compared to the so called 'weekend evolution of bacteria', where within two to three days the bacteria manage to activate a flagella to enhance their nutritional intake. As a result, they lost other properties. Adaptation comes at a price.
https://www.reading.ac.uk/news-archive/press-releases/pr624451.html
"But the hotwiring comes at a cost. The replacement key is a molecule borrowed from a system which regulates nitrogen levels. The mutant bacteria can now move, but it can't regulate nitrogen properly, which can build up and become toxic."
All the necessary information for these adaptation events is already coded in the bacteria. At population level, by using so called plasmids, they are able to share genetic information with each other, that they organize and utilize by using epigenetic mechanisms and factors.
Lenski's experiment proves that Darwinian mechanisms don't work. 68,000 generations is a huge number and the experiment is a nightmare for evolution believers. There are a lot of articles and papers regarding this long-term devolution experiment. For example:
Lenski's experiment proves that Darwinian mechanisms don't work. 68,000 generations is a huge number and the experiment is a nightmare for evolution believers. There are a lot of articles and papers regarding this long-term devolution experiment. For example:
https://www.logosra.org/lenski
"The bacteria have not experienced forward evolution, but rather the net effect has been reductive evolution (evolution going backwards). It is true that there has been some adaptation to the new artificial environment, but this has been primarily due to loss-of-function mutations. Such adaptive fine-tuning can at best be called microevolution, and has been accomplished through a net loss of information (broken genes/disrupted gene regulation). In all 12 experimental populations, the functional bacterial genome has shrunk - containing less total information. The resulting bacterial strains are still the same species, but have been seriously damaged. These disabled strains would quickly go extinct in any natural environment.
If any experiment could have validated large-scale macroevolution, it would have been this one. This famous experiment powerfully demonstrates that the mutation/selection process has very serious limitations. Even given huge populations and vast number of generations, all that was accomplished was a trivial amount of adaptive microevolution. Even while some superficial fine-tuning has been happening at just a handful of genomic sites, significant genetic damage has been accumulating throughout the rest of the genome, due to many slightly harmful deleterious mutations that cannot be selected away. This means that in the long run the net effect will be degeneration. This famous evolutionary experiment proves that in deep time, even given a model population that is optimal for validating evolution, populations do not evolve – but instead devolve - more"
"The bacteria have not experienced forward evolution, but rather the net effect has been reductive evolution (evolution going backwards). It is true that there has been some adaptation to the new artificial environment, but this has been primarily due to loss-of-function mutations. Such adaptive fine-tuning can at best be called microevolution, and has been accomplished through a net loss of information (broken genes/disrupted gene regulation). In all 12 experimental populations, the functional bacterial genome has shrunk - containing less total information. The resulting bacterial strains are still the same species, but have been seriously damaged. These disabled strains would quickly go extinct in any natural environment.
If any experiment could have validated large-scale macroevolution, it would have been this one. This famous experiment powerfully demonstrates that the mutation/selection process has very serious limitations. Even given huge populations and vast number of generations, all that was accomplished was a trivial amount of adaptive microevolution. Even while some superficial fine-tuning has been happening at just a handful of genomic sites, significant genetic damage has been accumulating throughout the rest of the genome, due to many slightly harmful deleterious mutations that cannot be selected away. This means that in the long run the net effect will be degeneration. This famous evolutionary experiment proves that in deep time, even given a model population that is optimal for validating evolution, populations do not evolve – but instead devolve - more"
Evolution has never happened. Don't get lost, dear friends.